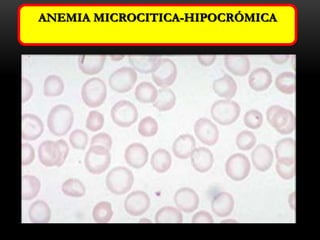
ANEMIA MICROCITICA-HIPOCRÓMICA

Necator americanus y Ancylostoma duodenale son los dos anquilostomas más comunes que infectan a los humanos, causando anemia del minero. Necator americanus se distingue de Ancylostoma duodenale por tener una cápsula bucal más pequeña con dos láminas en lugar de cuatro, y por tener un cuerpo más delgado y curvado en forma de S. Ambos parásitos se adhieren a la mucosa intestinal y succionan sangre, causando anemia microcítica e hipocromía en humanos. Se recomi